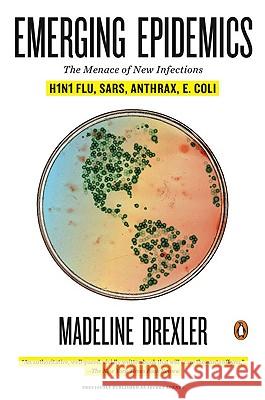
Emerging Epidemics: The Menace of New Infections

topmenu
Drexler, Madeline
Madeline Drexler is an award-winning journalist, author and travel essayist. She is editor of Harvard Public Health magazine and a senior fellow at Brandeis University's Schuster Institute for Investigative Journalism. Among her national honors: the 2012 Sigma Delta Chi Award for Public Service in Magazine Journalism; the 2012 Clarion Award for Feature Articles; and a 1996-1997 Knight Science Journalism Fellowship at MIT. Drexler's articles have appeared in The New York Times, The Wall Street Journal, The Nation, The American Prospect, The New Republic, The Los Angeles Times, The Boston Globe,...
Emerging Epidemics: The Menace of New Infections |  A Splendid Isolation: Lessons on Happiness from the Kingdom of Bhutan |  The World Exists to Set Us Free: Straight-Up Dharma for Living a Life of Awareness |










